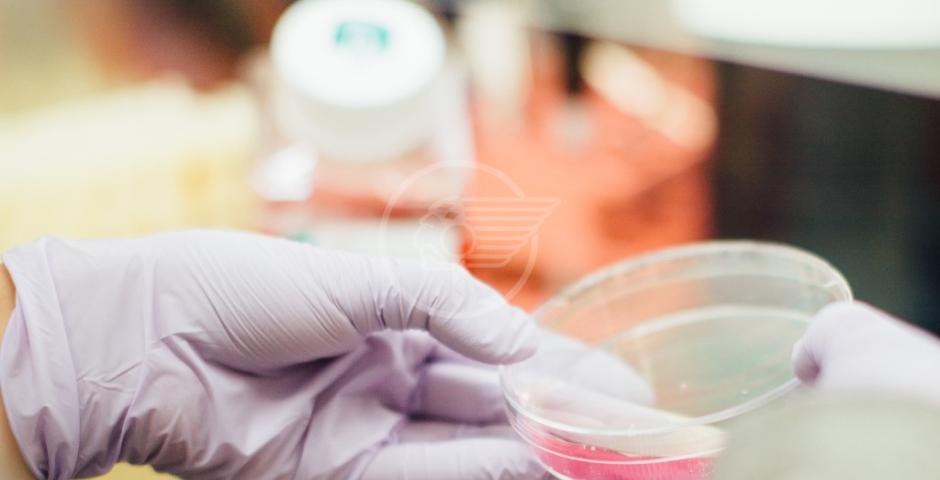

Dall’inizio dell’epidemia da Coronavirus, in Emilia-Romagna si sono registrati 38.695 casi di positività, 339 in più rispetto a ieri, su un numero record di tamponi eseguiti: 15.607.
Dei nuovi positivi, sono 160 gli asintomatici individuati nell’ambito delle attività di contact tracing e screening regionali. Prosegue l’attività di controllo e prevenzione: complessivamente 122 persone (tra i nuovi positivi) erano già in isolamento al momento dell’esecuzione del tampone e 162 sono stati individuati nell’ambito di focolai già noti.
L’età media dei nuovi positivi di oggi è 44,2 anni.
Sui 160 asintomatici, 83 sono stati individuati grazie all’attività di contact tracing, 19 attraverso i test per le categorie a rischio introdotti dalla Regione, 18 con screening sierologici, 7 con i test pre-ricovero. Per 33 casi è in corso la verifica sul motivo del tampone. Per quanto riguarda la situazione nelle province, i numeri più elevati si registrano in quelle di Bologna (69), Reggio Emilia (57), Rimini (50), Modena (49), Parma (30), Ferrara (30), Piacenza (17), a Cesena (12), Ravenna (10),
50 i nuovi casi in provincia di Rimini, di cui 29 asintomatici. Nel dettaglio: 39 sono contatti con casi certi, la maggior parte dei quali famigliari e già in isolamento al momento della diagnosi; 8 sono pazienti sporadici individuati per sintomatologia; 2 individuati con il test pre ricovero, a cui si aggiunge una persona rientrata dall’estero (Moldavia).
I tamponi effettuati ieri sono 15.607, per un totale di 1.326.602. A questi si aggiungono anche 2.855 test sierologici.
I casi attivi, cioè il numero di malati effettivi, a oggi sono 7.148 (272 in più di quelli registrati ieri).
Purtroppo, si registrano 4 nuovi decessi: uno in provincia di Bologna (una donna di 91 anni), uno in quella di Ferrara (un uomo di 83 anni), uno a Imola (un uomo di 82 anni) e uno in provincia di Modena (un uomo di 66 anni). Il numero totale sale dunque a 4.502.
Le persone in isolamento a casa, ovvero quelle con sintomi lievi che non richiedono cure ospedaliere o risultano prive di sintomi, sono complessivamente 6.730 (+208 rispetto a ieri), oltre il 95% dei casi attivi. Sono 35 i pazienti in terapia intensiva (+4 rispetto a ieri) e 383 (+60) quelli ricoverati negli altri reparti Covid.
Le persone complessivamente guarite salgono a 27.045 (+63 rispetto a ieri): 7 “clinicamente guarite”, divenute cioè asintomatiche dopo aver presentato manifestazioni cliniche associate all’infezione, e 27.038 quelle dichiarate guarite a tutti gli effetti perché risultate negative in due test consecutivi.
Questi i nuovi casi di positività sul territorio, che si riferiscono non alla provincia di residenza, ma a quella in cui è stata fatta la diagnosi: 5.437 a Piacenza (+17, di cui 9 sintomatici), 4.625 a Parma (+30, di cui 20 sintomatici), 6.178 a Reggio Emilia (+57, di cui 46 sintomatici), 5.411 a Modena (+49, di cui 27 sintomatici), 6.962 a Bologna (+69, di cui 24 sintomatici); 626 casi a Imola (+6, di cui 4 sintomatici), 1.656 a Ferrara (+30, di cui 8 sintomatici); 1.944 a Ravenna (+10, di cui 6 sintomatici), 1.640 a Forlì (+9, di cui 7 sintomatici), 1.271 a Cesena (+12, di cui 8 sintomatici) e 2.945 a Rimini (+50, di cui 20 sintomatici).



 Max 10°
Max 10°